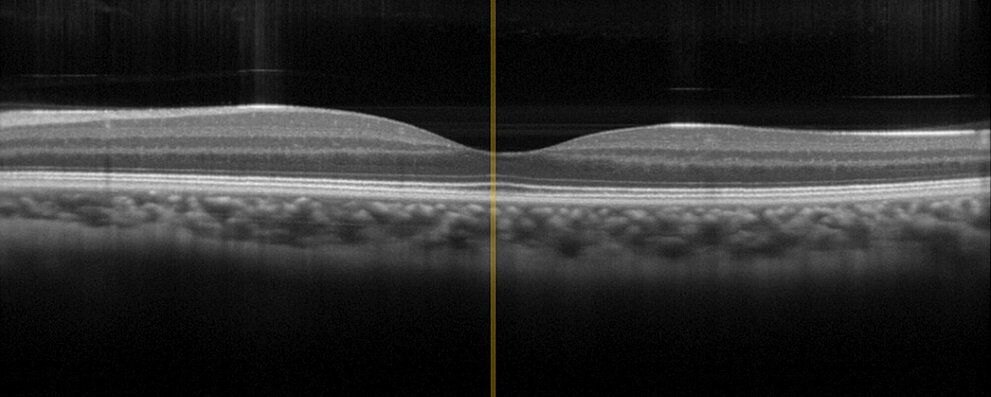
Physik Instrumente OCT Test Image

Advancing Surgical and Analytical Technology
Endoscopy and in vivo diagnostics are among the most sophisticated medical technologies since they are applied within or on the living organism. The highest reliability is indispensable here. PI's decades of experience as a supplier to companies in medical technology and the 30 years of experience as a manufacturer of piezo components are essential assets that PI contributes in the development and manufacture of assemblies and subsystems. For example, PI offers more than just one drive for variable focusing of chip-on-the-tip endoscopes. And for optical coherence tomography (OCT) with its applications in ophthalmology or dermatology, PI offers different drive technologies that can be adapted to device-specific requirements, such as size or travel range, for a precise positioning of the optics.